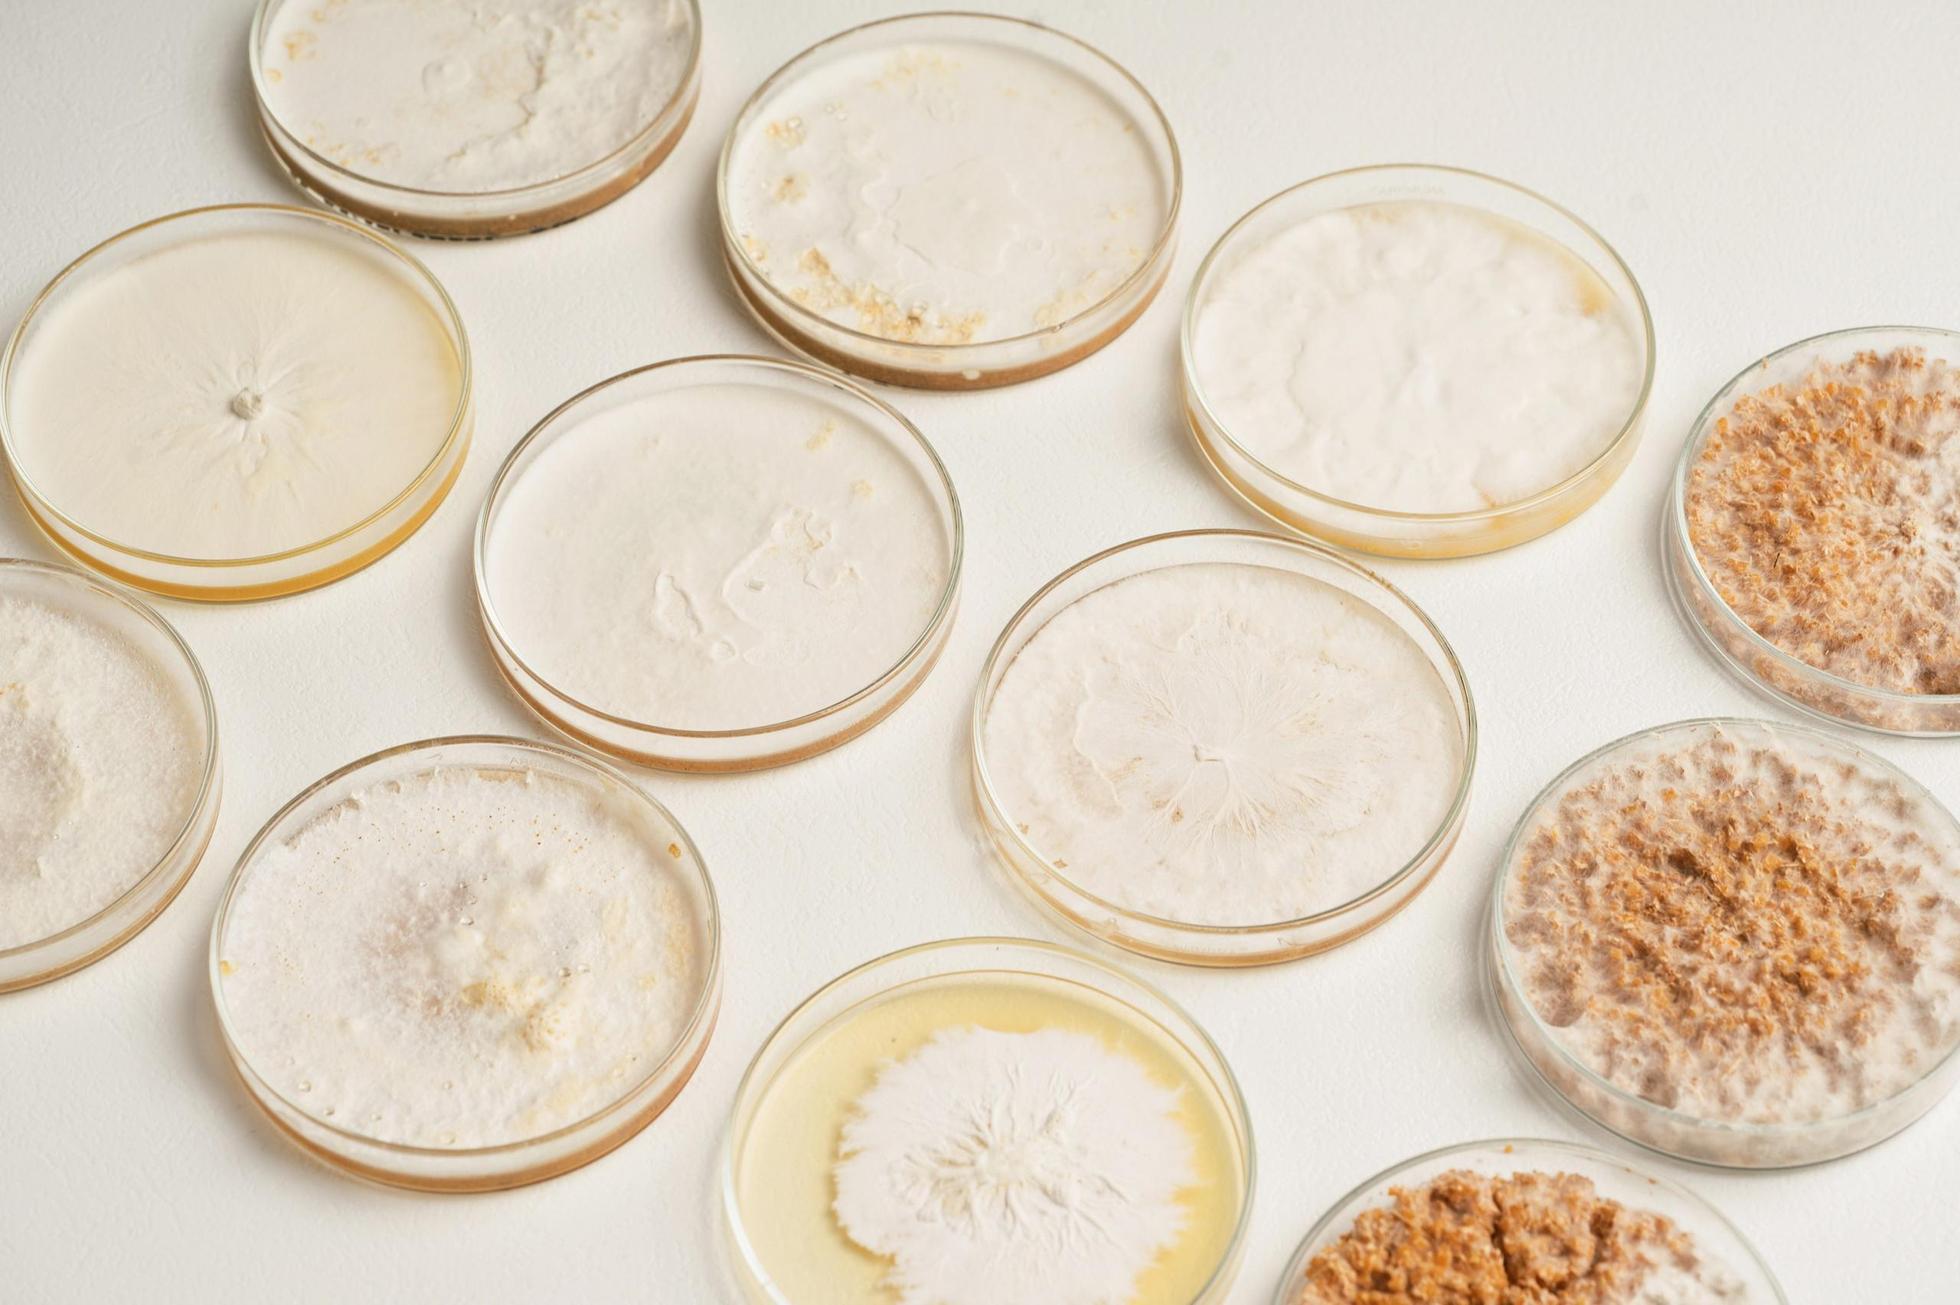

400万人が利用するビジネスSNS

東京
中途
オンライン面談OK
東京
中途
乾 馨太
「あきらめる必要なんてどこにある・誰が決めた?」 これは昔から私自身が自分に言い聞かせていた言葉です。 どんなに不遇な状況に生まれても、誠実で強い気持ちを持ちながら諦めずにやるべき事を真剣にこなしていければ必ずチャンスは巡ってくるし挽回できると確信しています。人生ってそういう風にできていると思います。
志賀 英人
「『諦める?いやいや、それ誰が決めたルールよ?』うちの代表、本気でこう思ってるから、新しいことへのチャレンジが大好きなんです(笑)。だからウチの営業も、『前例がないから…』とか『常識的に考えて…』みたいな壁は、むしろ『チャンスじゃん!』って捉えたい。誠実に、でも大胆に。強い気持ちでアクションし続ければ、お客様にとっても、自分たちにとっても、最高の未来が拓けるって信じてるから。もしあなたが『自分の手で新しい価値を生み出したい!』『停滞するより、ガンガン挑戦して成長したい!』ってタイプなら、きっとウチのチーム、めちゃくちゃ面白いと思いますよ!」
小渕 皇太
MYCLJapan株式会社のメンバー
「あきらめる必要なんてどこにある・誰が決めた?」
これは昔から私自身が自分に言い聞かせていた言葉です。
どんなに不遇な状況に生まれても、誠実で強い気持ちを持ちながら諦めずにやるべき事を真剣にこなしていければ必ずチャンスは巡ってくるし挽回できると確信しています。人生ってそういう風にできていると思います。
なにをやっているのか
きのこの栽培技術を応用し菌糸から皮のような新素材を開発。
意外と知られていないのが日本がキノコ栽培技術の世界的なパイオニア!
意外に思うかもしれませんが、きのこ栽培技術は環境負荷が非常に少ないんです!栽培時に農薬を一切使用せず、使用する材料も自然原料のみで栽培可能です!
しかも私たちが製造するKINOLI(皮調の新素材)は素材自体がすべて菌糸で出来ているため土に埋めると数週間で分解されます!
菌糸とは「きのこ」の基になり、植物で例えるなら根の部分です。その根部分を特殊処理して一枚のKINOLIが出来ています。KINOLIという名前にはKIN(きのこ)、NO(織物)、LI(ライフ)といったきのこで人生を豊かにしたいという私たちの思いが込められています!
きのこによって菌糸の特性も多種多様になり、自社グループ会社でKINOLI新素材としてふさわしい種菌の開発も手掛けています。きのこ好きの方にはもってこいの職場です!
私達はきのこ栽培技術の専門家としてきのこが環境を救うと信じ世の中に本当に環境の良い素材を提供していきます。






なにをやっているのか


きのこの栽培技術を応用し菌糸から皮のような新素材を開発。
意外と知られていないのが日本がキノコ栽培技術の世界的なパイオニア!
意外に思うかもしれませんが、きのこ栽培技術は環境負荷が非常に少ないんです!栽培時に農薬を一切使用せず、使用する材料も自然原料のみで栽培可能です!
しかも私たちが製造するKINOLI(皮調の新素材)は素材自体がすべて菌糸で出来ているため土に埋めると数週間で分解されます!
菌糸とは「きのこ」の基になり、植物で例えるなら根の部分です。その根部分を特殊処理して一枚のKINOLIが出来ています。KINOLIという名前にはKIN(きのこ)、NO(織物)、LI(ライフ)といったきのこで人生を豊かにしたいという私たちの思いが込められています!
きのこによって菌糸の特性も多種多様になり、自社グループ会社でKINOLI新素材としてふさわしい種菌の開発も手掛けています。きのこ好きの方にはもってこいの職場です!
私達はきのこ栽培技術の専門家としてきのこが環境を救うと信じ世の中に本当に環境の良い素材を提供していきます。
なぜやるのか


私達はきのこの可能性を信じるきのこ栽培技術関連企業が4社で作った国内初のグローバルJVです。
きのこ技術を突き詰めることが最終的には地球環境に貢献すると信じています。
また日本のきのこ栽培技術を守るべく、業界人として新しいことにチャレンジしていく姿勢を大事にしています。
循環型社会を目指し、限りある資源をどのように効率よく利用していくことが好ましいか?
私たちはきのこ栽培技術にその夢を追い求めています。
~~KINOLIとして~~
「環境負荷削減としての魅力」
- 一般的な動物皮革と比較し水の使用量が約1/4272
- 陸地の使用面積が約1/811(立体的に栽培できるため)
- 合皮と違い素材自体には石油由来の原材料不使用
- 収穫までの日数が約1/12(約60日で収穫できます)
- 収穫後の廃培地も菌糸ボードといった副産物に利用可能
~~キノコ栽培技術の特性~~
「Sustainable要素満載の魅力」
- 原材料はおが粉・ふすま・米ぬか・水のみ
*農薬等一切不使用がデフォルト
- 森林の二酸化炭素吸収量を最大限化する為にも定期的な間伐が必要。間伐材をおが粉にしきのこ栽培に活用することにより自然な循環の中で「きのこ」という恵みがあります。
- 廃培地も肥料に再利用可能
どうやっているのか

Yu Watanabe /designer collaboration

菌糸プロダクト-宇宙飛行士-
新しい産業を創出するにあたり参加メンバーの自由闊達な意見や行動を推奨しています。
企業風土は自由=責任感
新しい産業だからこそプレイヤーの感性が重要でKINOLI商品を魅力的にアピールでき、企業のノベルティー需要や環境意識の高い企業様へ採用していただけるようにしていきます。
5月中旬以降高輪ゲートウェイ・イノベーションセンター内にてサテライトオフィスを開業。
そこを営業チームの拠点とし、加速度的に新素材で作られた商品を販売していきたいと考えています。
こんなことやります
🌱 ポジション概要|KINOLI®セールス(東京エリア)
“売る”だけでなく、“育てる”営業へ
キノコ由来100%の新素材 KINOLI® を世に広げ、
パートナーと「循環型の新しい価値」を共創するフロントランナーを募集します。
まずは“話を聞きに”来ませんか?
🍄 ポジションの魅力
1. 未知の市場を切り拓くパイオニア体験
- 代替レザー市場は黎明期。成功事例を自ら創り出せます。
2. 語れる素材”でストーリーテリング営業
- 科学×デザイン×サステナビリティ。会話の糸口が尽きません。
3. AI × リモートで生産性を最適化
- 営業特化の AIを導入予定。コミュニケーションに集中できます。
4. スタートアップならではの裁量
- 企画提案から組織づくりまで、手を挙げた人が主役。
🍄具体的な業務内容
| 素材・製品販売|
BtoB(バッグ/小物メーカー)、ノベルティ提案、小売セレクトショップへの卸
| 共創開拓|
ポップアップ、展示会、建築・インテリア案件のコラボ提案
| 市場開発|
東京エリアを中心に新規顧客を発掘し、長期関係へ育成
| ストーリーテリング|
商談・ワークショップで菌糸の魅力をわかりやすく伝達
| AIツール活用|
営業リスト自動生成、提案書ドラフト、商談ログ解析 など
🍄歓迎するスキル・経験
- 法人/リテールいずれかの新規開拓営業(業界不問)
- 未知の人・場所に飛び込むのが好きなフットワーク
- プレゼン・ファシリテーション力(ワークショップ経験歓迎)
- AI/SaaS ツールを業務に取り入れた経験(歓迎)
└ ChatGPT、Geminiなど
- デザイン・クリエイティブ領域への興味(Adobe系スキル歓迎)
-キノコ・菌糸に興味。または好きな人
🍄 こんな人がフィットします 🧑🚀
- 探求心がとまらない:素材の裏側まで深掘りしないと気が済まない
- 思いやりがある:相手のストーリーも大切にできる
- 失敗を“経験”と呼べる:トライ & エラーを楽しみ、次に活かせる
- テクノロジーに前向き:AIを飼いならし、より良い対話に時間を割きたい
- 世代・職種の壁を越える:研究者・デザイナーともフラットに議論できる
- 情熱をもって取り組める:素材の良さを相手に伝えられる
🍄 入社後に期待する活躍
- 月5,000,000円の売り上げ早期達成
- 1 年後:月売上 10,000,000円規模を創出。
- 2 年後:営業チームをリードし、全国展開ロードマップを策定
🍄 働き方・制度
| 拠点 | 高輪ゲートウェイ駅徒歩 1分
| PC / ツール | MacBook or Windows 選択可、主要 SaaS・AI サブスク会社負担予定
まずは「話を聞きに行きたい」ボタンから、
KINOLI®の未来とあなたの可能性を一緒に語り合いましょう!
0人がこの募集を応援しています
0人がこの募集を応援しています
話を聞きに行くステップ
- 応募する「話を聞きに行きたい」から応募
- 会社からの返信を待つ
- 話す日程を決める
- 話を聞きに行く
募集の特徴
オンライン面談OK
会社情報


